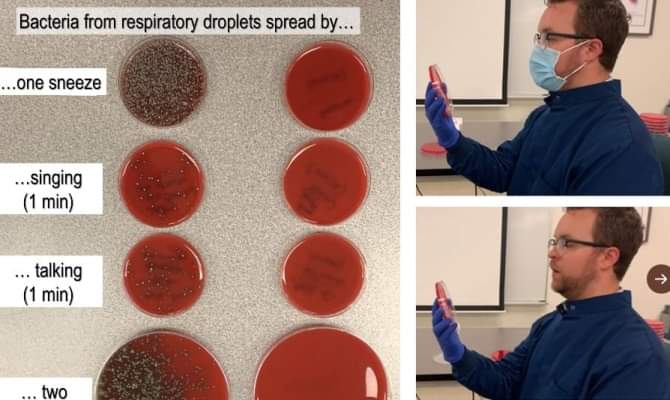
FB_IMG_1594751830511

Malo o maskama i znanosti

Nekidan su dr Rudan na RTLu, a dr Đikić na HRTu rasplakali naciju znanstveno nadahnutim nastupima o Covid-19. Prvi je govorio o važnosti nošenja krabulja, a drugi o nepogrešivoj znanosti.


Zajedno ćemo proći kroz „ultimativni pokus“ kojim je jedan nadobudni znanstvenik „začepio usta svima“ koji govore protiv maski. A dokazao je suprotno! Maske jesu opasne a znanstvenicima (sve češće) nedostaje pameti.

Što je on napravio. U mikrobiološki kontroliranim uvjetima postavio je niz bakterijskih hranilišta (posudice s agarom) na različitim udaljenostima i NAKAŠLJAO se ili s maskom ili bez nje. Kašljanjem bez maske, broj kolonija na hranilištima smanjivao se udaljenošću. S maskom nisu ni izrasle.
Isto je ponovio DISANJEM iznad hranilišta Ako je to činio bez maske, poraslo je mnoštvo kolonija, a s maskom značajno manje. Zaključio je da ima neoboriv dokaz kako maske štite od virusa.

Tako zaključuje 90% znanstvenika, stereotipnih proizvođača „sirovih“ podataka. Potvrdio je što znamo i bez pokusa. Prvo, „dokazao“ je postojanje „fiziološke“ bakterijske flore u ustima. Drugo, posredno je dokazao da maske preko usta postaju hranilišta za bakterije. Virusi se ovako ne mogu dokazati. Virusima za biološki pokus morate ponuditi posudice sa namnoženim stanicama (uz neki antibiotik da spriječi bakterijsku infekciju), a ne posudice s hranjivim agarom. Također, virusi NEĆE poput bakterija stvoriti kolonije, pune krugove. “Stvoriti” će prazne krugove jer će razoriti stanice! Neka pokuša tako. Držim mu iskreno držim fige!
Probavni trakt počinje ustima, mikrobiom sadrži i nekoliko kilograma „dobrih“ bakterija. Ako se „flora“ poremeti, „dobre“ bakterije valja nadoknaditi iz zdravstvenih razloga npr. probioticima. Kontrolirana „flora“ počinje u ustima. Kada izdisanjem dođe na hranilište, bakterije će se NEKONTROLIRANO namnožiti i stvoriti vidljive kolonije. Kada preko usta stavimo masku, s unutrašnje strane dužim nošenjem formirati će se hranilište koje će dobivati i potrebnu vlagu (u izdahnutom zraku vlaga je 100%!) i dotok organskih čestica. Na vlažnu i hranjivu podlogu prihvatiti će se bakterije, tu se zadržati i razmnožiti. Udisanjem preko maske, ove bakterije vraćati će se natrag u PLUĆA gdje prirodno ne bi smjele biti. Stalno reinficiranje zbog maski stvoriti će probleme i zdravima, a kamoli onima „načetim“ bezazlenim virusom prehlade. Npr. korona virusom! Primjerice, ako zbog upalnog procesa na punjenom zubu u krvotok duže vrijeme ulazi „flora“ iz usne šupljine, npr. Streptoccocus salivarius, možete oboliti od npr. smrtonosnog endokarditisa. Ako uđe u virozna pluća, zbog maske možete „zaraditi“ bakterijsku upalu. I baš to (!) je razlog što se preventivno, „na pamet“, uzimanje azitromicina pokazalo uspješnim u sprječavanju i „liječenju“ Covid-19! Iako antibiotikom nismo napali virus, nego bakterije!

Sutra idem na ljetovanje. Neka dr Đikić, dr Rudan, dr Markotić, dr Beroš, dr Božinović, dr RTL, dr Nova, dr HRT i ostali kovid-borci malo predahnu.
dr. SREĆKO SLADOLJEV
HOP












